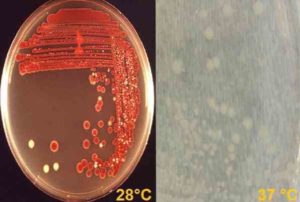
image
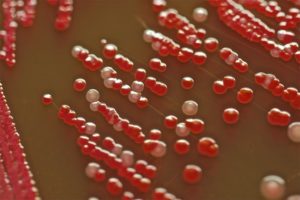
image

Мазок из зева на флору: что показывает анализ на чувствительность к антибиотикам и подготовка к нему, расшифровка результатов и их норма

Для определения причин развития болезней верхних дыхательных путей берут мазок из зева – этот метод диагностики позволит выявить тип возбудителя инфекционных, воспалительных процессов.
Чтобы анализ был точным, нужно правильно подготовиться к забору биологического материала.
Показания к процедуре
Мазок берут, чтобы изучить состав микрофлоры носоглотки, выявить возбудителя патологии, его чувствительность к антибиотикам.
В каких случаях назначают мазок:
- длительный насморк, который не проходит более 7 дней;
- аллергия;
- частые рецидивы фарингита, тонзиллита, ларингита;
- диагностика стрептококковой ангины;
- наличие проявлений инфекций, вызванных золотистым стафилококком;
- при подозрении на дифтерию, коклюш, менингит, грибковые патологии;
- туберкулёз;
- гайморит, аденоидит;
- мононуклеоз, абсцессы.
Мазок из зева входит в состав профилактического осмотра, анализ назначают детям, посещающим учебные учреждения, медработникам, лицам, которые работают с продуктами или в дошкольных и школьных заведениях.
Мазок на определение состава микрофлоры ЛОР-органов назначают всем беременным.
Соблюдение правил подготовки к сдаче мазка во многом определяет достоверность результатов.
Правила подготовки:
- за неделю прекратите принимать антибактериальные препараты в виде таблеток;
- за 5 дней откажитесь от использования спреев, мазей, ополаскивателей с антибактериальным и антисептическим действием;
- перед забором материала из ротоглотки нельзя есть, пить, жевать жвачку, курить, при необходимости сделать анализ полости рта противопоказано чистить зубы.
За неделю до сдачи анализа прекратите приём антибиотиков
Как правильно брать мазок и зева и носа?
На достоверность анализа влияет и профессионализм медицинского персонала, при погрешностях во время взятия, хранения и транспортировки биоматериала результат бакпосева будет недостоверным.
Техника проведения процедуры:
- Пациент широко открывает рот, запрокидывает голову.
- Медсестра стерильным или одноразовым шпателем надавливает на язык, ватным тампоном собирает слизь, налёт со слизистых глотки, поверхностей миндалин.
- Полученный материал помещают в пробирку с питательным раствором, который позволяет сохранить жизнеспособность бактерий в процессе транспортировки.
- Полученный биоматериал отправляют в лабораторию, время доставки не более 2 часов.
Взятия мазка – безболезненная, но неприятная процедура, надавливание на язык может спровоцировать приступ рвоты, особенно если материал берут у ребёнка.
Перед исследованием слизистой полости носа удаляют слизь, корки, кожные покровы ноздрей смазывают медицинским спиртом. Пациент немного запрокидывает голову, стерильным тампоном проводят поочерёдно по стенкам правого и левого носовой хода. Собранные в пробирку образцы, отправляют в лабораторию.
Методики изучения биоматериала
При микроскопическом исследовании полученный биоматериал окрашивают по Грамму, изучают после обработки иммерсионными маслами. Метод позволяет выявить грамположительные, грамотрицательные бактерии, кокковую флору, коккобацилл.
Бактериологический посев – один из основных методов диагностики, поскольку каждый микроорганизм может размножиться только в определённой среде, при комфортном уровне pH и влажности, при исследовании важно соблюдать полную стерильность.
Бактериологический посев – основной вид диагностики для выявления патогенных микроорганизмов
Если обнаружен рост микрофлоры, обязательно проводят тесты на антибиотикочувствительность, многие микробы способны быстро вырабатывать иммунитет к лекарствам – на фоне неэффективной терапии развиваются тяжёлые осложнения.
Мазок-отпечаток – специфический анализ для изучения состав клеток слизистой в носу. Образец наносят на предметное стекло, подсчитывают число эозинофилов, других частиц. Исследование назначают при предрасположенности к аллергии.
При неэффективности антибактериальной терапии делают тесты на фагочувствительность. Результат позволяет подобрать бактериофаги для устранения проявлений инфекционных патологий – это современные противомикробные препараты, которые вызывают гибель только определённых видов бактерий.
Расшифровка результатов анализа
На слизистых каждого человека обитает около 50 полезных микробов, представителей сапрофитной и условно-патогенной микрофлоры, изучение отделяемого из горла и носа позволяет определить количественное соотношение и состав этиологически значимых микроорганизмов.
Список микробов
| Безопасные микроорганизмы: | Опасные микроорганизмы |
|
|
Результат вписывают в бланк, в нём указывают род, вид, количество микроорганизмов, уровень патогенности. После определения типа возбудителя проводят тесты на определение чувствительности микробов к антибактериальным средствам, бактериофагам.
Отрицательный результат свидетельствует об отсутствии грибков и болезнетворных бактерий, это означает, что инфекция имеет вирусное происхождение. Положительный результат наблюдается при наличии опасных микроорганизмов, или активном росте представителей условно-патогенной микрофлоры.
По времени бактериологическое исследование занимает 5–7 дней, в экстренных случаях делается экспресс-тест для выявления антигенов к бактериям, грибкам, результат можно получить уже через полчаса.
О чём говорят повышенные показатели
Наличие большого количества грибков и бактерий в мазке – признак развития ЛОР-заболеваний, каждый микроорганизм провоцирует определённые патологии.
Превышение нормы стафилококков наблюдается чаще всего у детей
Какие болезни вызывают патогенные микроорганизмы:
- стафилококки – фарингит, тонзиллит, гингивит, синусит, активный рост бактерий чаще всего наблюдается у детей и людей преклонного возраста;
- стрептококки – ангина, скарлатина, синусит;
- грибки рода кандида – кандидоз ротовой полости, нередко сопровождается осложнениями, которые затрагивают органы дыхательной системы;
- пневмококки, нейссерии – воспаление лёгких, бронхит, отит среднего уха, остеомиелит, болезни верхних дыхательных путей, ротоглотки;
- дифтерийная коклюшная палочка, в норме бактерии в мазке отсутствуют, при положительном результате определяют уровень концентрации микробов, чтобы сделать заключение о степени развития патологии;
- гемолитический стрептококк – тяжёлые формы ангины, которые практически всегда дают осложнения на сердце.
При показателях более 10*5–10*7 КОЕ/мл вероятность развития воспалительных, инфекционных, гнойных процессов максимальная. Сливной результат – очень высокое содержание патогенных микробов, их количество невозможно посчитать, наблюдается при тяжёлых и запущенных формах заболеваний, требуется срочная антибактериальная терапия.
Мазок из носоглотки – эффективный метод диагностики заболеваний ЛОР-органов, определяет тип возбудителя патологического процесса, стадию развития болезни, позволяет подобрать эффективные методы терапии и снизить риск развития осложнений.
Характеристики, таксономия, патология и симптомы Serratia marcescens / биология
Serratia Marcescens является грамотрицательной палочкой, оппортунистическим патогеном, принадлежащим к семейству Enterobacteriaceae. Эта бактерия была ранее известна под именем Bacillus prodigiosus, но позже он был переименован в Serratia Marcescens.
Вид Marcescens является наиболее важным из рода Serratia, потому что он был связан с большим разнообразием оппортунистических инфекций у людей. Когда-то этот микроорганизм использовался в качестве безвредного маркера загрязнения окружающей среды, но сегодня он считается инвазивным микроорганизмом..
Известно, что в последние десятилетия хаос в больничной среде, особенно в палатах интенсивной терапии и контрольно-пропускных пунктах. Он был изолирован от мокроты и посевов крови у пациентов, получающих химиотерапию. Также в образцах мочи и CSF.
Таким образом, он был возбудителем пневмонии, сепсиса, инфекций мочевыводящих путей, детского менингита и других. Некоторые вспышки были вызваны загрязнением растворов, предметов и инструментов для использования в больницах..
Тем не менее, вне внутрибольничной среды также может вызвать инфекцию. Было видно, что 8% случаев язвенного кератита вызваны Serratia Marcescens. Кроме того, это было связано с ухудшением качества некоторых продуктов, богатых крахмалом..
индекс
- 1 Характеристики
- 1.1 Общая характеристика и условия роста
- 1.2 Биохимические характеристики
- 1.3 Факторы вирулентности
- 1.4 Устойчивость к противомикробным препаратам
- 2 Таксономия
- 3 Морфология
- 4 Патологии и симптомы
- 5 Диагноз
- 6 Лечение
- 7 ссылок
Общие характеристики и условия роста
Serratia Marcescens Это факультативная аэробная палочка, подвижная, как и большинство энтеробактерий. Это вездесущий обитатель почвы, воды и поверхности растений. Поэтому обычно его можно найти во влажных средах, таких как ванные комнаты, водостоки, раковины, раковины и т. Д..
Он способен существовать в неблагоприятных условиях. Например, он может расти при температуре от 3,5 до 40 ° С. Кроме того, он может выживать в хлоргексидиновом мыльном растворе до концентрации 20 мг / мл..
В лаборатории это может расти при комнатной температуре (28 ° C), где у некоторых разновидностей развивается характерный пигмент кирпично-красных разновидностей, названных продигиозином. Но он также растет при 37 ° C, где его колонии имеют кремово-белый цвет, то есть при этой температуре он не образует пигмент.
Это представляет физиологическое фенотипическое изменение, стимулируемое температурой. Эта характеристика уникальна для этой бактерии, поскольку ни один другой вид семейства не способен это сделать..
Производство пигмента, несомненно, является очень полезным инструментом для постановки диагноза..
Что касается диапазона pH, который может поддерживать, это колеблется от 5 до 9.
Биохимические характеристики
Биохимически говоря Serratia Marcescens соответствует основным характеристикам, которые описывают полное семейство Enterobacteriaceae, то есть он ферментирует глюкозу, восстанавливает нитраты до нитритов и является отрицательной оксидазой.
Теперь у него есть другие биохимические характеристики, которые описаны ниже:
S. marcescens положительные тесты: Voges-Proskauer, цитрат, подвижность, лизин декарбоксилаза, орнитин и O-нитрофенил-β-D-галактопиранозид (ONPG) и каталаза.
В такой же степени это отрицательно сказывается на: производстве сероводорода (H2S), индол, фенилаланин-деаминаза, мочевина и аргинин.
Столкновение с метиловым красным тестом может быть переменным (положительным или отрицательным).
Наконец, перед поллиглигером происходит щелочная / кислотная реакция, то есть ферментируется глюкоза с образованием газа, но не лактоза..
Факторы вирулентности
Род Serratia выделяется в этом семействе, потому что он имеет 3 важных гидролитических фермента: липазу, желатиназу и внеклеточную ДНКазу. Эти ферменты способствуют инвазивной способности этого микроорганизма.
Он также содержит 3 хитиназы и белок, связывающий хитин. Эти свойства важны при деградации хитина в окружающей среде..
Кроме того, киназы предоставляют собственность S. marcescens противогрибкового действия на грибы Zygomycetes, клеточная стенка которых состоит в основном из хитина.
С другой стороны, S. marcescens Он способен формировать биопленки. Это представляет значительный фактор вирулентности, поскольку в этом состоянии бактерия более устойчива к действию антибиотиков..
Недавно было обнаружено, что некоторые штаммы S. marcescens они представляют систему секреции типа VI (T6SS), которая служит для секреции белков. Однако его роль в вирулентности еще не определена.
Устойчивость к противомикробным препаратам
Штаммы S. marcescens продуценты хромосомных бета-лактамаз AmpC.
Это дает им внутреннюю устойчивость к ампициллину, амоксициллину, цефокситину и цефалотину, поэтому единственным вариантом среди бета-лактамов для лечения штаммов, продуцирующих ESBL, являются карбапенемы и пиперациллин тазобактам..
Кроме того, он обладает способностью приобретать механизмы устойчивости к другим обычно используемым антибиотикам, в том числе аминогликозидам..
Штаммы S. marcescens производители кпк-2 и бла тэм-1. В этом случае карбапенемы уже не эффективны.
Первый штамм КПК за пределами больницы был изолирован в Бразилии, он был устойчив к азтреонаму, цефепиму, цефотаксиму, имипенему, меропенему, гентамицину, ципрофлоксацину и цефазидиму и был чувствителен только к амикацину, тигециклину и гатифлоксацину.
таксономия
Домен: Бактерии
Тип: протеобактерии
Класс: гамма-протеобактерии
Заказ: Энтеробактерии
Семья: энтеробактерии
Племя: клебсиеллы
Жанр: Серратия
Виды: Марсесенс.
морфология
Это длинные бациллы, которые, в отличие от окраски по Граму, окрашены в красный цвет, то есть они являются грамотрицательными. Не образует спор. У них есть чрескожные жгутики и липополисахарид в клеточной стенке.
Патологии и симптомы
Среди патологий, которые могут вызвать Serratia Marcescens У ослабленных больных имеются: инфекция мочевыводящих путей, инфекция ран, артрит, конъюнктивит, эндофтальмит, кератоконъюнктивит и язвенный кератит..
Кроме того, это может вызвать более серьезные патологии, такие как: сепсис, менингит, пневмония, остеомиелит и эндокардит.
Ворот к этим патологиям обычно представлен загрязненными растворами, венозными катетерами с образованием биопленки или другими загрязненными инструментами..
В случае офтальмологических патологий это главным образом вызвано использованием контактных линз, заселенных этой или другой бактерией. В этом смысле язвенный кератит является наиболее серьезным офтальмологическим осложнением, которое возникает у тех, кто носит контактные линзы. Характеризуется потерей эпителия и стромальной инфильтрацией, что может привести к потере зрения.
Другим менее агрессивным офтальмологическим проявлением является синдром CLARE (острый красный глаз, вызванный контактными линзами). Этот синдром проявляется острой болью, фотофобией, слезотечением и покраснением конъюнктивы без повреждения эпителия.
диагностика
Они растут в простых средах, таких как питательный агар и инфузия сердца, на обогащенных средах, таких как кровяной агар и шоколад.
В этих средах колонии имеют тенденцию становиться кремово-белыми, если они инкубируются при температуре 37 ° C, в то время как при комнатной температуре колонии могут иметь красно-оранжевый пигмент..
Они также растут на селективной среде и дифференциальном агаре Макконки. В этом случае колонии становятся бледно-розовыми или бесцветными при 37 ° С, а при 28 ° С они увеличивают оттенок своего цвета.
Агар Müeller Hinton используется для выполнения антибиограммы.
лечение
Из-за естественной устойчивости этой бактерии к пенициллинам и цефалоспоринам первого поколения следует использовать другие антибиотики, если они чувствительны к антибиограмме и механизмы резистентности, такие как продуцирование бета-лактамаз расширенного спектра, среди других, отсутствуют..
Среди антибиотиков, которые могут быть проверены для определения их восприимчивости:
- Фторхинолоны (ципрофлоксацин или лебофлоксацин),
- Карбапенемы (эртапенем, имипенем и меропенем),
- Цефалоспорины третьего поколения (цефотаксим, цефтриаксон или цефадроксил),
- Цефалоспорин четвертого поколения (цефепим),
- Аминогликозиды (амикацин, гентамицин и тобрамицин),
- Хлорамфеникол особенно полезен в случаях инфекций, в которых участвует образование биопленок.
ссылки
- Юм Е, Уиллкокс М. Явление Serratia Marcescens как глазной патоген поверхности. Arch Soc Esp Oftalmol. 2004; 79 (10): 475-481
- Райан К.Дж., Рэй С. Sherris. микробиология Medical, 2010. 6th Ed. McGraw-Hill, New York, U.S.A.
- Koneman, E, Allen, S, Janda, W, Schreckenberger, P, Winn, W. (2004). Микробиологический диагноз. (5-е изд.). Аргентина, редакция Panamericana S.A..
- Hover T, Maya T, Ron S, Сандовский H, Шадкчан Y, Кийнер Н., Митягин Y и соавт. Механизмы бактериального (Serratia MarcescensПривязанность, миграция и гибель грибных гиф. Appl Environ Microbiol. 2016; 82 (9): 2585-2594.
- Участники Википедии. Serratia Marcescens. Википедия, Свободная энциклопедия. 14 августа 2018 года, 16:00 UTC. Взято с wikipedia.org.
- Сандреа-Толедо Л., Паз-Монтес А., Пинья-Рейес Е., Перозо-Мена А. Энтеробактерии, продуцирующие β-лактамазы расширенного спектра, выделенные из культур крови, в университетской больнице Венесуэлы. Kasmera. 2007; 35 (1): 15-25. Доступно по адресу: Scielo.org
- Мердок С., Ствол К., Английский Г., Фрич М., Поуркарими Е. и Култхерст С. Оппортунистический патоген Serratia Marcescens Использует секрет VI типа для борьбы с бактериальными конкурентами. Журнал бактериологии. 2011; 193(21): 6057-6069.
- Маргейт E, Магальес V, Фельберг I, Уэльс А и Лопес. KPC-производство Serratia Marcescens у пациента по уходу на дому из Ресифи, Бразилия. Журнал Do Институт тропической медицины Сан-Паулу, 2015; 57(4), 359-360.
Энтеробактер: что это такое, чем опасно для человека

Энтеробактеры представляют собой грамотрицательные бактерии, имеющие форму палочек, покрытых жгутиками. Они не образуют спор, развиваются в анаэробных условиях, но способны выживать в присутствии кислорода. Большинство данных микроорганизмов входят в состав нормальной кишечной микрофлоры человека и животных, а некоторые обитают в воде, почве и продуктах питания.
Энтеробактер под микроскопом выглядит как палочка со жгутиками
Типичные представители энтеробактерий
Бактерии рода Enterobacter относятся к семейству enterobacteriaceae и включают в себя 12 видов, относящихся преимущественно к условно патогенной флоре, населяющей кишечник человека. Наибольший интерес для медиков имеют энтеробактеры, которые при определенных условиях способны вызывать заболевания у людей.
- Enterobacter cloacae является представителем нормальной микрофлоры дистального отдела кишечника. Но после приема антибиотиков, при снижении иммунитета или развитии дисбактериоза, его усиленное размножение приводит к нарушению работы ЖКТ. Из-за непосредственной близости ануса к наружным половым органам у женщин может происходить инфицирование, приводящее к вагинитам, цервицитам и воспалениям других отделов мочеполовой системы. Развитие микроорганизмов в дыхательных путях приводит к тяжелой форме пневмонии, а вот проникновение их в кровяное русло вызывает септицемию.
- Enterobacter aerogenes чаще других микробов является причиной больничных инфекций. Особую опасность представляет инфицирование внутрисосудистых катетеров, шунтов и протезов, провоцирующее инфекционный эндокардит, тромбофлебит или общий сепсис.
- Enterobacter agglomerans, обозначенные в современной литературе термином Pantoea agglomerans, поражают преимущественно органы мочеполовой системы мужчин и женщин, а также респираторный тракт.
- Enterobacter sakazakii, отнесенный в последнее время к роду Cronobacter, представляет большую опасность для новорожденных детей, особенно, имеющих недостаточную массу тела, аномалии развития и врожденные заболевания иммунной системы. Доказано, что Энтеробактер саказаки вызывает инфекционное воспаление оболочек головного и спинного мозга, образование некротических очагов на стенках кишечника, явления сепсиса.
- Enterobacter gergoviae, переименованный в Pluralibacter gergoviae, вызывает кишечные расстройства, поражения органов выделения, дыхания и размножения.
Другие условно патогенные бактерии рода энтеробактер, к которым относятся Enterobacter asburiae, Enterobacter hormaechei, Enterobacter ludwigii и Enterobacter kobei поражают преимущественно ЖКТ и респираторные органы.
https://youtube.com/watch?v=qpkRtWat1DA
Обнаружить микроб можно в разных средах человеческого организма
Иногда в результатах анализов встречается термин «лактозонегативные энтеробактерии», что указывает на наличие микроорганизмов, препятствующих правильному перевариванию продуктов и вызывающих изжогу, метеоризм, диарею, срыгивание и другие диспептические явления. В составе нормальной микрофлоры их количество не должно превышать 5%.
Таксономическая принадлежность
Род: Enterobacter
Семейство: Enterobacteriaceae
Группа: V грамотрицательные факультативные анаэробы
Отдел: I грамотрицательные микроорганизмы
Царство: Prokaryote
Название рода было утверждено в 1963 году. Но проведенные в последующем исследования генома привели к существенным изменениям в систематике. В результате этого E.agglomerans выделили в отдельный род Pantoea, а E.sakazakii отнесли к роду Cronobacter.
Поэтому современная классификация включает 12 видов бактерий рода энтеробактер, из которых наибольшее эпидемиологическое значение имеют энтеробактер клоака и аэрогенес.
Строение, жизненный цикл и свойства микробов
По внешнему строению энтеробактеры напоминают прямые палочки. Их тело полностью покрыто жгутиками, обеспечивающими движение. Единственным неподвижным видом является E.asburiae.
Выращивание в лабораторных условиях позволяет выявить Enterobacter в анализах
Диаметр микроорганизмов колеблется от 0,6 до 1 мкм, а длина — от 1.2 до 3 мкм.
При диагностическом исследовании в мазках обнаруживаются единичные или соединенные в короткие цепочки бактерии.
Все представители кишечной группы рода энтеробактер быстро растут на стандартных и селективно-дифференциальных питательных средах.
Бактерии принадлежат к группе факультативных анаэробов, не образуют спор, но у некоторых штаммов имеются капсулы. Местом их обитания являются слизистые оболочки кишечного тракта, органов мочеполовой системы и дыхания. При этом микроорганизмы способны выживать в экскрементах, почве, водоемах, на растениях, кожных покровах животных и других объектах внешней среды.
Род энтеробактер становится заразен для людей в период снижения резистентности организма или после длительного курса антибиотикотерапии. В первую очередь ускоряется пролиферация Enterobacter cloacae в тонком кишечнике, что для данных бактерий не характерно, так как большинство их населяет толстый отдел.
Энтеробактеры опасны для новорожденных младенцев с ослабленным иммунитетом в период прохождения через родовые пути. Инфицирование человека может произойти при попадании большого количества микроорганизмов с недоброкачественными продуктами питания или при заглатывании воды в открытых водоемах.
Низкая чувствительность к антибиотикам у представителей энтеробактер приводит к тому, что они быстро замещают лакто- и бифидобактерии, количество которых резко снижается во время продолжительного применения человеком антибиотиков. Такой дисбактериоз приводит к возникновению заболеваний.
Лабораторная диагностика: что означают цифры
У взрослого человека в кишечнике содержание микроорганизмов рода энтеробактер, включающих в себя Enterobacter cloacae, aerogenes и другие виды, не должно превышать 104 колониеобразующих единиц на 1 г кала.
Бактерии энтеробактер в кале ребенка появляется с первых дней жизни, но его количество и соотношение с другими микроорганизмами будет постоянно изменяться, так как в первые 3-4 месяца идет интенсивное заселение кишечника. Искусственное введение в организм малыша бифидо и лактобактерий позволяет поддерживать баланс микрофлоры кишечника.
При выявлении у новорожденных детей пневмонии, возникает подозрение на инфицирование их во время прохождения родовых путей.
В этом случае у матери в мазке из цервикального канала обнаруживается Enterobacter aerogenes с концентрацией более 105КОЕ.
Чтобы предотвратить такой путь заражения беременным проводят бакпосев на обнаружение Enterobacter aerogenes, Cronobacter sakazakii и некоторых других микроорганизмов, выявляемых при обычном бакпосеве.
https://youtube.com/watch?v=-27XjdDRMuA
Инфицирование ребенка может произойти, если в грудном молоке матери высеян энтеробактер, концентрация которого превышает допустимые показатели. Однако диагноз подтверждается после возникновения характерных клинических признаков и обнаружении Enterobacter cloacae в кале у ребенка в количестве, превышающем 104КОЕ.
Анализ мочи проводится для выяснения причин возникновения урогенитальных инфекций и выявления скрытых воспалений почек и мочевого пузыря.
Если при отсутствии клинических симптомов у женщин концентрация энтеробактер в 1 мл мочи превышает 105КОЕ, то диагноз подтверждается, и назначается курс лечения.
Если же количество в моче Enterobacter cloacae ниже данного показателя, то это свидетельствует о загрязнении лабораторного материала во время его забора.
Если клиника заболевания имеет выраженный характер, то допустимый порог в 1 мл мочи составляет не более Enterobacter cloacae 10 в 4 степени.
Делая посев из зева, следует знать, какая норма энтеробактер аэрогенес должна быть у человека, так как ее превышение может спровоцировать тяжелую форму пневмонии. Если показатель превышает Enterobacter aerogenes 10 2КОЕ и сопровождается клиническими признаками, то следует начинать немедленное лечение.
Пациенты, у которых выявлено наличие энтеробактера клоаке в горле, но не имеющие симптомов поражения респираторного тракта, считаются носителями. У них значительно повышается риск возникновения пневмонии при попадании в условия стационара, так как на ее долю приходится 10% случаев от совокупности внутрибольничных инфекций.
Для определения рисков инфекции разработаны стандарты лабораторной диагностики
Норма энтеробактер клоаке в зеве составляет от 102 до 104КОЕ, но при этом их количество не должно значительно превышать концентрацию других форм нормальной микрофлоры.
В чем опасность для человека
Наибольшую опасность энтеробактеры представляют для новорожденных, так как вызывают:
- менингит;
- гнойное воспаление почек и мочевыводящих путей;
- некротический колит;
- тяжелые поражения кровеносной и лимфатической системы;
- гнойничковые и язвенные поражения кожи у грудничков.
Летальность при этом составляет от 55 до 80%.
Респираторные заболевания, вызванные Enterobacter cloacae, которые локализуются в горле, проявляются повышением температуры тела, слабостью и продуктивным кашлем.
Опасность данных инфекционных заболеваний заключается в том, что даже при грамотной своевременной терапии могут наблюдаться параличи, резкое падение кровяного давления, приводящее к потере сознания, асфиксия. Смертность составляет до 25%.
Энтеробактеры являются возбудителями бактеремий, при которых происходит интенсивное размножение микроорганизмов в крови, приводя к развитию патологий во всех внутренних органах.
У мужчин бактерии рода энтеробактер часто вызывают простатиты и уретриты. У женщин они становятся причиной воспалений органов мочеполовой системы, которые очень тяжело поддаются лечению.
Наиболее восприимчивыми являются люди, перенесшие серьезные травмы, больные сахарным диабетом, а также другими болезнями, подавляющими синтез клеток иммунитета.
Особенности лечения
Так как представители рода Enterobacter spp.
устойчивы ко многим антимикробным препаратам, то перед началом лечения необходимо установить чувствительность выделенного микроорганизма к конкретному антибиотику.
Далее назначается комплексная терапия, позволяющая, как избавиться от представителей энтеробактер и устранить симптомы вызванного ими заболевания, так и повысить общую резистентность организма.
С этой целью применяются аминогликозиды, Бета-лактамы, тетрациклины и цефалоспорины 3-го поколения. Наиболее широкое применение в борьбе с энтеробактер клоаке и аэрогенес нашел Метронидазол, Пиперациллин, Цефтриаксон, Ко-амоксиклав, Гентамицин.
Целесообразны комбинации антимикробных препаратов и средств, потенцирующих их действие. Но такое совмещение может назначаться только врачом после получения результатов лабораторных анализов.
Инновацией в лечении заболеваний, вызванных энтеробактерами, является применение бактериофага Энтеробактер поливалентного очищенного. Ранее ученым не удавалось создать бактериофаг, какой бы объединял несколько фагов рода энтеробактер, включающих в себя Э.
клоака, Э. аэрогенес и Э. аггломеранс, отделенных от метаболитов бактерий.
Его эффективность доказана при следующих патологиях:
- ЛОР-заболевания;
- гастроэнтероколиты;
- хирургические гнойные инфекции;
- пневмонии;
- дисбактериоз;
- заболевания мочеполовой сферы у мужчин и женщин.
Данный препарат может применяться детям с первых дней жизни.
Другим проверенным средством против бактерий энтеробактер является бактериальный Секстафаг, воздействующий также на стафилококки, стрептококки, протеи, клебсиеллы и кишечную палочку.
Прежде, чем лечить заболевания, вызванные Enterobacter aerogenes у беременной женщины, следует знать о возможных патологиях, развивающихся у плода при приеме следующих лекарственных средств:
- нитрофураны: гемолитическая анемия;
- сульфаниламиды: желтуха и гемолитическая анемия;
- аминогликозиды: отрицательное влияние на слух и работу почек;
- нитроксолин: атрофия зрительного нерва.
Поэтому, выбирая, чем лечить инфекции, спровоцированные энтеробактер аэрогенес пациенткам в период вынашивания плода, медики отдают предпочтение пенициллинам и цефалоспоринам в сочетании с пробиотиками и щадящим рационом питания.
Лечение болезней, вызванных возбудителями энтеробактер, средствами народной медицины сводится к усилению иммунитета, восстановлению баланса микрофлоры кишечника, а также дезинфекции ротовой полости и влагалища у женщин. С этой целью применяются травяные сборы, в состав которых входит ромашка, зверобой, кора дуба, полынь, шалфей и некоторые другие травы.
Перед использованием любых народных методов необходимо проконсультироваться с врачом, так как самолечение может скрыть клинические симптомы заболевания, и инфекция перейдет в хроническую форму или вызовет осложнения.
Работаю врачом ветеринарной медицины. Увлекаюсь бальными танцами, спортом и йогой. В приоритет ставлю личностное развитие и освоение духовных практик. Любимые темы: ветеринария, биология, строительство, ремонт, путешествия. Табу: юриспруденция, политика, IT-технологии и компьютерные игры.
Патогенные энтеробактерии: условное исследования на другие бактерии у грудничка, их характеристика и анализ кала для этого
В желудочно-кишечном тракте обитает множество условно-патогенных бактерий. При крепком иммунитете они не вызывают никаких патологий у человека.
Но как только защитные силы организма ослабевают, эти микробы начинают проявлять свои болезнетворные свойства. Одной из таких бактерий является Enterobacter cloacae.
Описание
Бактерии Enterobacter cloacae (Энтеробактер клоаке) представляют собой микроорганизмы палочковидной формы. Они не способны образовывать споры.
Эти бактерии являются анаэробными, они могут жить при полном отсутствии кислорода. Энтеробактеры довольно устойчивы к воздействию дезрастворов и большинства антибиотиков. Они содержатся в большом количестве в окружающей среде и попадают в организм чаще всего с пищей.
Ингалятор компрессорный: обзор лучших моделей, рейтинг, характеристики, инструкция, отзывы о производителях
Эти бактерии являются частью нормальной микрофлоры ЖКТ. Если их количество не превышает допустимые показатели, то никаких патологий у человека не возникает. Однако при падении иммунитета происходит активное размножение энтеробактеров, что может спровоцировать различные заболевания.
Патогенность
При неблагоприятных условиях микроорганизмы Enterobacter cloacae могут вызывать воспалительные процессы в разных органах. Обычно это происходит при резком ослаблении организма или на фоне других заболеваний. Бактерии могут поражать не только ЖКТ, но и другие органы: легкие, почки, мочевой пузырь. Это приводит к появлению следующих патологий:
- дисбактериоза кишечника;
- острого пиелонефрита;
- цистита;
- аспирационной пневмонии.
Активно размножаясь, энтеробактеры вытесняют полезные микроорганизмы. В результате у человека нарушается микрофлора в органах ЖКТ. Это приводит к ухудшению самочувствия, дальнейшему снижению иммунитета и высокой подверженности инфекциям.
Анализ кала
Как выявить чрезмерное размножение Enterobacter cloacae? Это можно сделать с помощью анализов кала или мочи на бакпосев. Рассмотрим эти исследования более подробно.
https://youtube.com/watch?v=UmxLYQ_7brE
Концентрацию Enterobacter cloacae в кале определяют во время проведения анализа на дисбактериоз кишечника. Это исследование назначают, если у пациента имеются следующие симптомы:
- длительное повышение температуры до +38 градусов;
- периодическая рвота;
- диарея;
- примесь крови и слизи в испражнениях.
На пробу берут небольшой кусочек биоматериала, желательно с примесью слизи или крови (если есть). Кал необходимо доставить в лабораторию в течение 1 часа.
Специалисты проводят посев фекалий на питательные среды. Через 5 дней бактерии в биоматериале начинают размножаться. После этого подсчитывается количество микроорганизмов в 1 г кала. Их концентрацию измеряют в КОЕ (колониеобразующих единицах).
Исследование мочи
Для определения содержания Enterobacter cloacae в моче назначают анализ урины на бакпосев. Это исследование показано в следующих случаях:
- при беременности;
- при обнаружении бактерий или грибков в общем анализе мочи;
- при сахарном диабете;
- при признаках воспаления в органах выделения;
- при хроническом цистите, уретрите и пиелонефрите.
За 7 дней до проведения пробы нужно исключить из рациона острые, соленые и жирные блюда, а также спиртные напитки. За 2 недели до сдачи анализа необходимо прекратить прием антибиотиков.
Перед сбором мочи нужно тщательно вымыть наружные половые органы, не используя при этом антибактериальное мыло. Урину собирают утром в аптечный контейнер и доставляют в лабораторию в течение 2 часов. Затем проводится посев мочи на питательные среды. После этого определяется количество бактерий в 1 мл урины.
Нормы и расшифровка результатов
Каковы нормы содержания энтеробактеров в анализе кала? Максимально допустимая концентрация Enterobacter cloacae — 10 в степени 4 (104) колониеобразующих единиц (КОЕ) на 1 г биоматериала.
Превышение этой нормы может быть признаком дисбактериоза. Однако врач всегда обращает внимание на содержание в анализе и других видов условно-патогенных кишечных бактерий:
- клебсиелл;
- протеев;
- гафний;
- провиденций;
- морганелл;
- цитробактеров;
- серраций.
Повышение концентрации вышеперечисленных микроорганизмов и энтеробактеров свидетельствует о дисбиозе.
Рассмотрим расшифровку анализа мочи на бакпосев:
- Если результаты исследования показавают концентрацию энтеробактеров до 103 микробных тел на 1 мл, то человек здоров. Такие данные анализа являются нормой.
- При показателях более 104 энтеробактеров на 1 мл врач может подозревать инфекцию органов выделения. В этом случае необходимо пройти дополнительную диагностику.
- Если в расшифровке анализа показатель энтеробактеров превышает 105 микробных тел на 1 мл, то врач диагностирует истинную бактериурию.
Энтеробактериоз кишечника
Повышение концентрации Enterobacter cloacae в кале у ребенка — нередкое явление. Усиленное размножение таких бактерий в 50 % случаев диагностируется у детей в возрасте до 6 месяцев. Если содержание условно-патогенных микроорганизмов превышает допустимую норму, то врачи ставят диагноз — энтеробактериоз кишечника.
В детском возрасте эта патология протекает в довольно тяжелой форме. Она сопровождается следующей симптоматикой:
- стойким повышением температуры;
- беспокойством и плачем;
- отказом от еды;
- диареей, сменяющейся запорами;
- тошнотой и рвотой;
- выделением зловонных испражнений с примесью крови и слизи.
Острые проявления заболевания могут продолжаться от 7 до 10 дней. У взрослых энтеробактериоз протекает с такими же симптомами, как и у детей, но в более легкой форме.
Бактериурия
Если у пациента в моче отмечается концентрация энтеробактеров выше 105 микробных тел, то такое отклонение называется бактериурией. Оно может указывать на воспалительные процессы в органах выделения. Если это состояние протекает без выраженных клинических проявлений, то врачи говорят о бессимптомной бактериурии.
Если же у человека имеются явные симптомы воспаления в почках или мочевом пузыре (болевой синдром, высокая температура, расстройства мочеиспускания), то отклонением от нормы считается показатель энтеробактеров выше 104 микробных тел.
При этом врачи обращают внимание и на данные общего анализа мочи. Повышение концентрации энтеробактеров и количества лейкоцитов чаще всего свидетельствуют о пиелонефрите.
Лечение
Что делать, если в анализе кала обнаружено повышенное количество Enterobacter cloacae? Лечение энтеробактериоза у взрослого или ребенка должно быть комплексным. Медикаментозная терапия обязательно сочетается с соблюдением диеты.
Необходимо исключить из рациона сладости, мед, дрожжи, жареную и соленую еду. Такая пища способствует размножению условно-патогенной микрофлоры. Нужно стараться употреблять как можно больше кисломолочных продуктов, в их состав входят полезные лактобактерии.
Если обнаружена Enterobacter cloacae у ребенка в возрасте до 12 месяцев, то родителям необходимо тщательно следить за гигиеной малыша. Дети нередко инфицируются повторно сами от себя.
Поэтому нужно несколько раз в день кипятить соску и игрушки-грызунки. Ребенка необходимо тщательно подмывать после каждой дефекации. Это поможет предотвратить самозаражение и рецидивы энтеробактериоза.
Что касается питания, то самой лучшей едой для грудничка с энтеробактериозом является материнское молоко. С разрешения педиатра допускается прикорм в виде соков.
При энтеробактериозе назначают следующие группы лекарств:
- Пробиотики: «Линекс», «Бифидумбактерин», «Бифиформ». Они содержат живые штаммы полезных бактерий.
- Пребиотики: «Хилак Форте». В состав этих препаратов входят вещества, способствующе размножению полезных микроорганизмов.
- Синбиотики: «Гастрофарм», «Нормофлорин-Л». Эти средства содержат полезные бактерии и питательные вещества для их роста.
При выраженных диспепсических явлениях (рвоте, диарее) показан прием энтеросорбентов: «Смекты», «Энтеросгеля», «Полифепана», «Фильтрума».
Антибиотики назначают только при тяжелых формах энтеробактериоза. Условно-патогенные микроорганизмы довольно устойчивы к воздействию антибактериальных лекарств. Поэтому перед лечением необходимо провести тест на чувствительность микрофлоры к антибиотиков. Это поможет правильно подобрать препарат.
Если у пациента выявлены энтеробактеры в моче, то лечение будет зависеть от клинических проявлений. Бессимптомная бактериурия далеко не всегда требует медикаментозной терапии. Необходимость назначения лекарств может определить только врач.
Если же у пациента имеются симптомы пиелонефрита, уретрита или цистита, то необходимо сделать тест на чувствительность бактерий к антибиотикам, а затем пройти курс антибактериальной терапии.
Энтеробактерии
Энтеробактерии (лат. enterobacteriaceae) — семейство грамотрицательных (как и другие протеобактерии) палочкообразные (бациллы), споронеобразующие бактерии, длиной 1-5 мкм, со жгутиками для передвижения.
Эти бактерии — факультативные анаэробы, расщепляют углеводы с образованием муравьиной кислоты и других конечных продуктов формиатного брожения. Некоторые из них могут разлагать лактозу.
Множество представителей семейства являются частью микрофлоры кишечника человека и животных. Они представляют большое число нормальной микрофлоры человеческого организма и значительное количество патогенных микробов: сальмонелла, кишечная палочка, чумная палочка и др.





